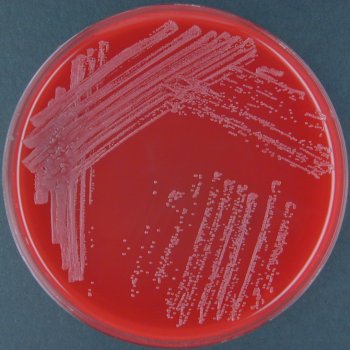

Yersinia pseudotuberculosis

- filomorfik, 30ºC ‘nin altında hareketli, kapsülsüz bakterilerdir.(Bkz; Yersinia) (Bkz; pseudo–tuberculosis)
- Hayvanlar aleminde yayılmışlardır.En çok kemiriceler ve kuşlarda görülür.
- Avrupada akut Gastroenteritislerin %1’ine Yersinia enterocolitica ile birlikte sebep olurlar.
Hastalık belirtileri
- Gastrointestinal enfeksiyon
- Enterokolitis (6 yıldan az sürer)
- Akut mezenteriyal lenfadenit
- Terminale Ileitis, psödo apandisit
- Septikemi
- Metastik enfeksiyonlar
- fokal apse
- Endokarditis
- Osteomyelitis
- Enfeksiyon sonrası, immün patolojik reaksiyonlar
- Büyük eklemlerde artrid
- Myokarditis
- Erythema nodosum
Tedavi
- Kendiliğinden iyileşme mümkündür.
- Antibiyotik
- Fluorchinolone
- Cephalosporine(3. nesil)

